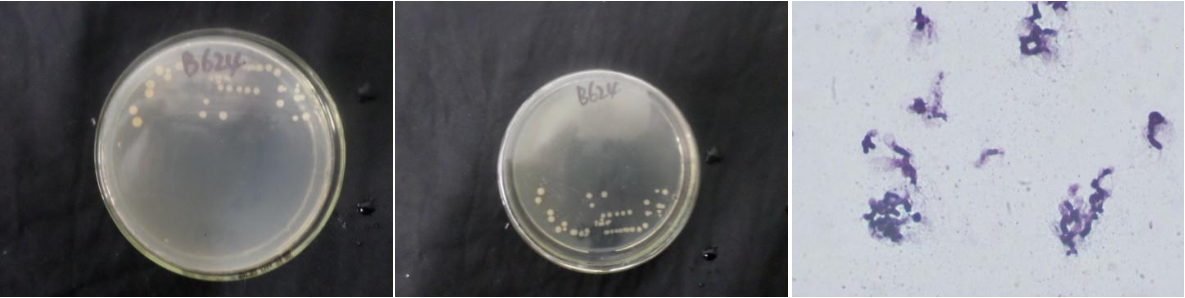

Loading...
| StrainNO | B624 |
| Classification | Falsibacillus |
| 16s rDNA sequence | TCCTAAGCTTACTTATTCGACTTCCCCCATCATCTGTCCCACCTTAGGCGGCTGGCTCCAAAAGGTTACCTCACCGACTTCGGGT GTTACAAACTCTCGTGGTGTGACGGGCGGTGTGTACAAGGCCCGGGAACGTATTCACCGCGGCATGCTGATCCGCGATTACTAGC GATTCCAGCTTCATGCAGGCGAGTTGCAGCCTGCAATCCGAACTGAGAACGGTTTTATGGGATTTGCTAAACCTCGCGGTCTTGC TGCCCTTTGTACCGTCCATTGTAGCACGTGTGTAGCCCAGGTCATAAGGGGCATGATGATTTGACGTCATCCCCACCTTCCTCCG GTTTGTCACCGGCAGTCATCTTAGAGTGCCCAACTGAATGCTGGCAACTAAGATCAAGGGTTGCGCTCGTTGCGGGACTTAACCC AACATCTCACGACACTAGCTGACGACAACCATGCACCACCTGTCACTCTGTCCCCCGAAGGGGAAAGCCCTATCTCTAGGGTTGT CAGAGGATGTCAAGACCTGGTAAGGTTCTTCGCGTTGCTTCGAATTAGACCACATGCTCCACCGCTTGTGCGGGCCCCCGTCAAT TCCTTTGAGTTTCAGTCTTGCGACCGTACTCCCCAGGCGGAGTGCTTAATGCGTTAGCTGCAGCACTAAAGGGCGGAAACCCTCT ACACTTAGCACTCATCGTTTACGGCGTGGACTACCAGGTATCTAATCCTGTTTGCTCCCCACGCTTTCGCGCCCTCAGCGTCAGT TACATACCAGAAAGTCGCCTTCGCCACTGGTGTTCCTCCACATATCTACGCATTCACCGCTACCGTGGAATTCCACTTTCTTCTT CTGTACTCAAGTCCCCAGTTCCATGACCCTCACGGTTGAGCGTGGGCTTCACATCAGACTTAGAGAACCGCTGCTCGCGCTTTAG CCCAGAATTCCGACAACGCTGCACCTACGTTTACGCGGCTGCCTGGACCATAATAACCAGGCCTCT |
| Strain Morphology Photos | |
| Morphological Description | Colony round;Soybean juice yellow;edge neatly;steamed bun shaped;slippy;sticky;Waxed;Rod;having spore;Mesophilic budding spore |